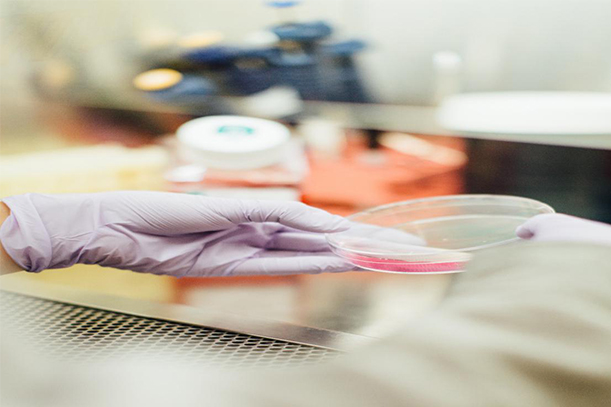

SibFU scientists have synthesized a sorbent based on chemically modified silica using commercially available reagents. The new material is capable of concentrating and extracting most rare earth elements from solutions, and the amount of sorbent used is relatively small.
Rare earth elements (REE) are strategic metals, widely used in various high-tech devices: lasers, magnets, computers, cell phones, aircraft construction, and communication systems. The main rare earth stocks are located in China and the USA. The increasing demand for rare earths and Russia’s ambition for industrial sovereignty contribute to the development of its own sources of rare metals, as well as the use of recyclables: industrial waste, ash from coal burning, etc. The studied sorbents can be used in laboratories for the analysis of complex samples containing REE when direct tool-based determination is problematic.
„Methods for determining low concentrations of rare earths in complex natural objects and their derivatives are now in demand. In soil, coals, and ash, the content of rare earths is relatively small, but there are large quantities of accompanying elements that interfere with the analysis. Therefore, for example, direct atomic-emission or mass spectrometry detection of rare earths may be difficult. To eliminate unwanted interference, it is necessary to isolate and concentrate rare earth metals,” informed Olga Buyko, senior researcher at the Laboratory of Physical Chemistry of Metallurgical Processes and Materials, SibFU.
The sorption concentration method makes it possible to extract trace amounts of REE from solutions on a relatively small amount of sorbent, separate them from elements that interfere with the detection (calcium, magnesium, potassium, sodium, iron, etc.), then release rare earths from the surface of the sorbent with dilute aqueous solutions of inorganic acids, and then detect them by atomic spectrometric methods.
SibFU scientists were the first to use silica for the concentration and determination of rare earths in fossil wood (lignite) and in ash. Silica is a sorbent based on silicon oxides, chemically modified with aminophosphonic groups with different surface concentrations. According to Olga Buyko, the more such groups are grafted onto silica, the larger the area of acidity becomes for the extraction of rare earths, which means that they can be more effectively separated from their accompanying components.
SibFU experts tested the sorbent in preliminary concentration and subsequent detection of lanthanides in lignite samples and coal ash. The scientists analyzed two samples of lignite from the Kasskoye deposit located near the Yenisey River and ash from their combustion.
Lignites are unique natural objects, which are carbonized wood containing from 150 to 500 g/t of rare earths, depending on the location. Lignites also contain alkali and alkaline-earth metals, iron, zinc, nickel, which make it difficult to directly determine REE by atomic spectroscopic methods.
“There are analogues of such sorbents in the world, but it has not been studied before how exactly the concentration of aminophosphonic groups grafted on the sorbent affects the extraction of rare earths”, — Olga Buyko said.
As a result of the experiment, it turned out that an increase in the concentration of grafted aminophosphonic groups on the sorbent makes it possible to extract rare earth elements from more acidic media and significantly pumps the sorbent, increasing its sorption capacity and selectivity.
The scientists noted that the studied sorbent is easily-obtain and efficient. It can be synthesized using commercially available starting aminopropyl silica gels.
Source: https://indiaeducationdiary.in/siberian-federal-university-experts-to-propose-an-effective-way-to-extract-and-determine-rare-earth-metals/